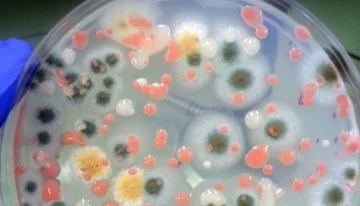
Descubren microbios desconocidos para la ciencia en la Estación Espacial Internacional

Un grupo de investigadores de EE.UU. y la India, que trabajan con la NASA, han descubierto cuatro cepas de bacterias que viven en diferentes lugares de la Estación Espacial Internacional (EEI), tres de las cuales eran, hasta ahora, completamente desconocidas para la ciencia. Su estudio ha sido publicado en la revista Frontiers in Microbiology.
Tres de las cuatro cepas fueron aisladas en 2015 y 2016: una se encontró en un panel superior de la estación de investigación; la segunda, en la cúpula; la tercera, en la superficie de la mesa del comedor. Mientras, la cuarta se halló en un antiguo filtro de aire HEPA devuelto a la Tierra en 2011.
Si bien una cepa se identificó como Methylorubrum rhodesianum, las otras tres no se habían descubierto previamente. Al ser secuenciadas, los expertos encontraron que todas pertenecen a una nueva especie y denominaron a las variedades como IF7SW-B2T, IIF1SW-B5 e IIF4SW-B5. No obstante, sus análisis genéticos revelaron que todas están estrechamente relacionadas con Methylobacterium indicum.
El equipo ha propuesto llamar a la nueva especie Methylobacterium ajmalii en honor a Ajmal Khan, un reconocido investigador indio de la biodiversidad. Según el estudio, el hallazgo también está estrechamente relacionado con una especie ya conocida llamada M. indicum.
De esta manera, las cuatro cepas pertenecen a la familia de bacterias Methylobacterium, cuyos ejemplares se encuentran en el suelo y el agua dulce. Estos microorganismos participan en la fijación de nitrógeno, el crecimiento de las plantas y pueden ayudar a detener los patógenos en la vegetación.
Los astronautas que viven en la estación han estado cultivando pequeñas cantidades de alimentos durante años, por lo que no es sorprendente que hayan aparecido microbios relacionados con las plantas a bordo de la EEI.
"Para cultivar plantas en lugares extremos donde los recursos son mínimos, el aislamiento de nuevos microbios que ayudan a promover el crecimiento de las plantas en condiciones estresantes es esencial", explicaron en un comunicado los miembros del equipo.
Tomando en cuenta que estos microorganismos pueden sobrevivir a las duras condiciones de la EEI, los científicos sometieron las cuatro cepas a un análisis genético para buscar características que puedan "contribuir al desarrollo de cultivos de plantas autosostenibles para misiones espaciales a largo plazo en el futuro".